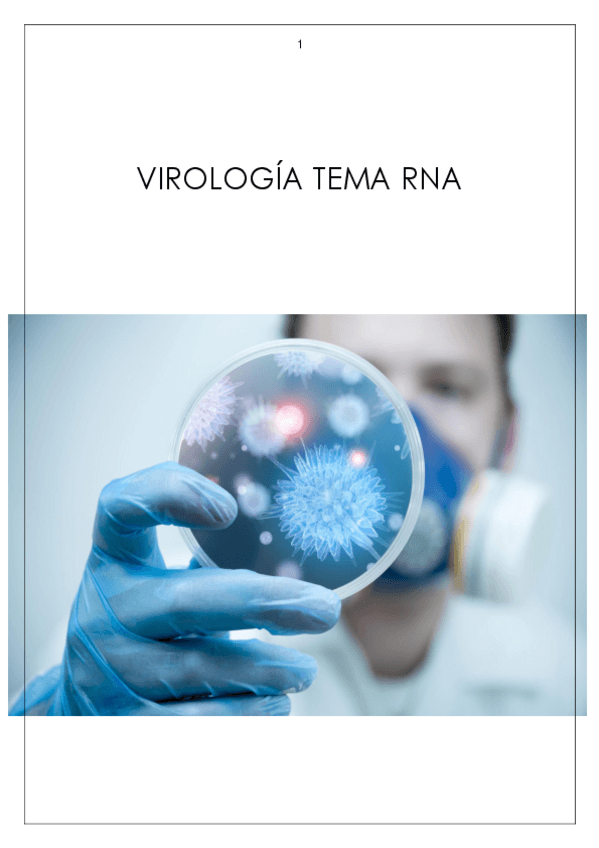

@gopharmacy
40 Publicaciones
1.86k Interacciones
3 Seguidores
4 Siguiendo
Lista de publicaciones de gopharmacy
He publicado nuevos practicas de 4º Bioquímica Clínica i Hematologia: Memoria-Bioquimica.pdf
He publicado nuevos ejercicios de 4º Bioquímica Clínica i Hematologia: TUTORIA-2-bq.pdf
He publicado nuevos practicas de 4º Análisis Microbiológicos y Parasitológicos: Memoria-Analisis.pdf
ejercicios
-
Seminarios Dietoterapia
He publicado nuevos ejercicios de 3º Terapia de Dieta: Seminarios Dietoterapia
He publicado nuevos ejercicios de 3º Terapia de Dieta: Tutoria-celiaquia.pdf
He publicado nuevos ejercicios de 3º Terapia de Dieta: Tutoria-de-la-sal.pdf
He publicado nuevos ejercicios de 3º Nutrición y Bromatología: Tutoria-2.pdf
He publicado nuevos ejercicios de 3º Nutrición y Bromatología: TUTORIA-3.pdf
He publicado nuevos ejercicios de 3º Nutrición y Bromatología: Tutoria-1-Etiqueta.pdf
He publicado nuevos practicas de 2º Análisis Químico: EsquemasPracticasAnalisis.pdf
He publicado nuevos apuntes de 2º Microbiología: tema-20-arreglado-Recuperado-automaticamente.pdf
He publicado nuevos practicas de 1º Biología General: Practica-osmosis.pdf